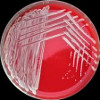

Для уточнения цены и услуги выберите подраздел в начале страницы.
Запись
200₽
+7(383 ..показать +7(499) 11-68-239+7(383) 389-19-43 +7(383) 309-29-00
Многоклиника на Новогодней Новосибирск; ул. Новогодняя, д. 23/2 ; м. Студенческая
Запись
200-1500₽
+7(812 ..показать +7(499) 11-68-239+7(812) 561-45-68
XXI век на Коллонтай 4 Санкт-Петербург; ул. Коллонтай, д. 4 ; м. Проспект Большевиков
Запись
200-1500₽
+7(812 ..показать +7(499) 11-68-239+7(812) 561-45-68
XXI век на проспекте КИМа Санкт-Петербург; пр-т КИМа, д. 28 ; м. Приморская
Запись
200-1500₽
+7(812 ..показать +7(499) 11-68-239+7(812) 561-45-68
XXI век на Щербакова Санкт-Петербург; ул. Щербакова, д. 11 ; м. Удельная
Запись
200-1500₽
+7(812 ..показать +7(499) 11-68-239+7(812) 561-45-68
XXI век на Коломяжском проспекте Санкт-Петербург; Коломяжский пр-т, д. 28 ; м. Пионерская
Запись
200-1500₽
+7(812 ..показать +7(499) 11-68-239+7(812) 561-45-68
XXI век на Большом Сампсониевском проспекте Санкт-Петербург; Большой Сампсониевский пр-т, д. 45 ; м. Выборгская
Запись
200-1500₽
+7(812 ..показать +7(499) 11-68-239+7(812) 561-45-68
XXI век на Старо-Петергофском проспекте Санкт-Петербург; Старо-Петергофский пр-т, д. 39А ; м. Нарвская
Запись
200-1500₽
+7(812 ..показать +7(499) 11-68-239+7(812) 561-45-68
XXI век на Пограничника Гарькавого Санкт-Петербург; ул. Пограничника Гарькавого, д. 15, корп. 3 ; м. Проспект Ветеранов
Запись
400-820₽
+7(499 ..показать +7(499) 11-68-239
СМ-Клиника на Маршала Захарова Санкт-Петербург; ул. Маршала Захарова, д. 20 ; м. Ленинский проспект
Запись
400-510₽
+7(495 ..показать +7(499) 11-68-239+7(495) 407-03-65
СМ-Клиника на Сенежской Москва; ул. Сенежская, д. 1/9 ; м. Речной Вокзал
Запись
400-820₽
+7(499 ..показать +7(499) 11-68-239
СМ-Клиника на Малой Балканской Санкт-Петербург; ул. Малая Балканская, д. 23 ; м. Купчино
Запись
400-820₽
+7(499 ..показать +7(499) 11-68-239
СМ-Клиника на проспекте Ударников Санкт-Петербург; пр-т Ударников, д. 19 ; м. Ладожская
Запись
400-820₽
+7(499 ..показать +7(499) 11-68-239
СМ-Клиника на Выборгском шоссе Санкт-Петербург; Выборгское шоссе, д. 17, корп. 1 ; м. Проспект Просвещения
Запись
616-1093₽
+7(499 ..показать +7(499) 11-68-239
Клиника на Театральной Санкт-Петербург; наб. Крюкова канала, д. 8 ; м. Садовая
Запись
690-1150₽
+7(383 ..показать +7(499) 11-68-239+7(383) 389-54-91
Клиника НИИТО на Фрунзе 19А Новосибирск; ул. Фрунзе, д. 19А ; м. Красный проспект
Запись
700-2135₽
+7(499 ..показать +7(499) 11-68-239+7(499) 322-42-92
МедСемья на Фестивальной Москва; ул. Фестивальная, д. 20, корп. 2 ; м. Речной Вокзал
Запись
750-1120₽
+7(499 ..показать +7(499) 11-68-239
MedSwiss на проспекте Обуховской Обороны Санкт-Петербург; пр-т Обуховской Обороны, д. 120Б ; м. Пролетарская
Запись
1000-1100₽
+7(495 ..показать +7(499) 11-68-239+7(495) 233-71-03 +7(495) 233-00-83 +7(495) 233-00-14
Гастроцентр на Берзарина Москва; ул. Берзарина, д. 12 ; м. Октябрьское Поле
Запись
1300-1750₽
+7(499 ..показать +7(499) 11-68-239
РАМИ на Кирочной Санкт-Петербург; ул. Кирочная, д. 13 ; м. Чернышевская
Запись
6000₽
+7(495 ..показать +7(499) 11-68-239+7(495) 645-33-77
Ильинская больница в Глухово Московская область; д. Глухово, ул. Рублевское предместье, д. 2, корп. 2 ;
Ещё клиник - 2943 . Используйте фильтры